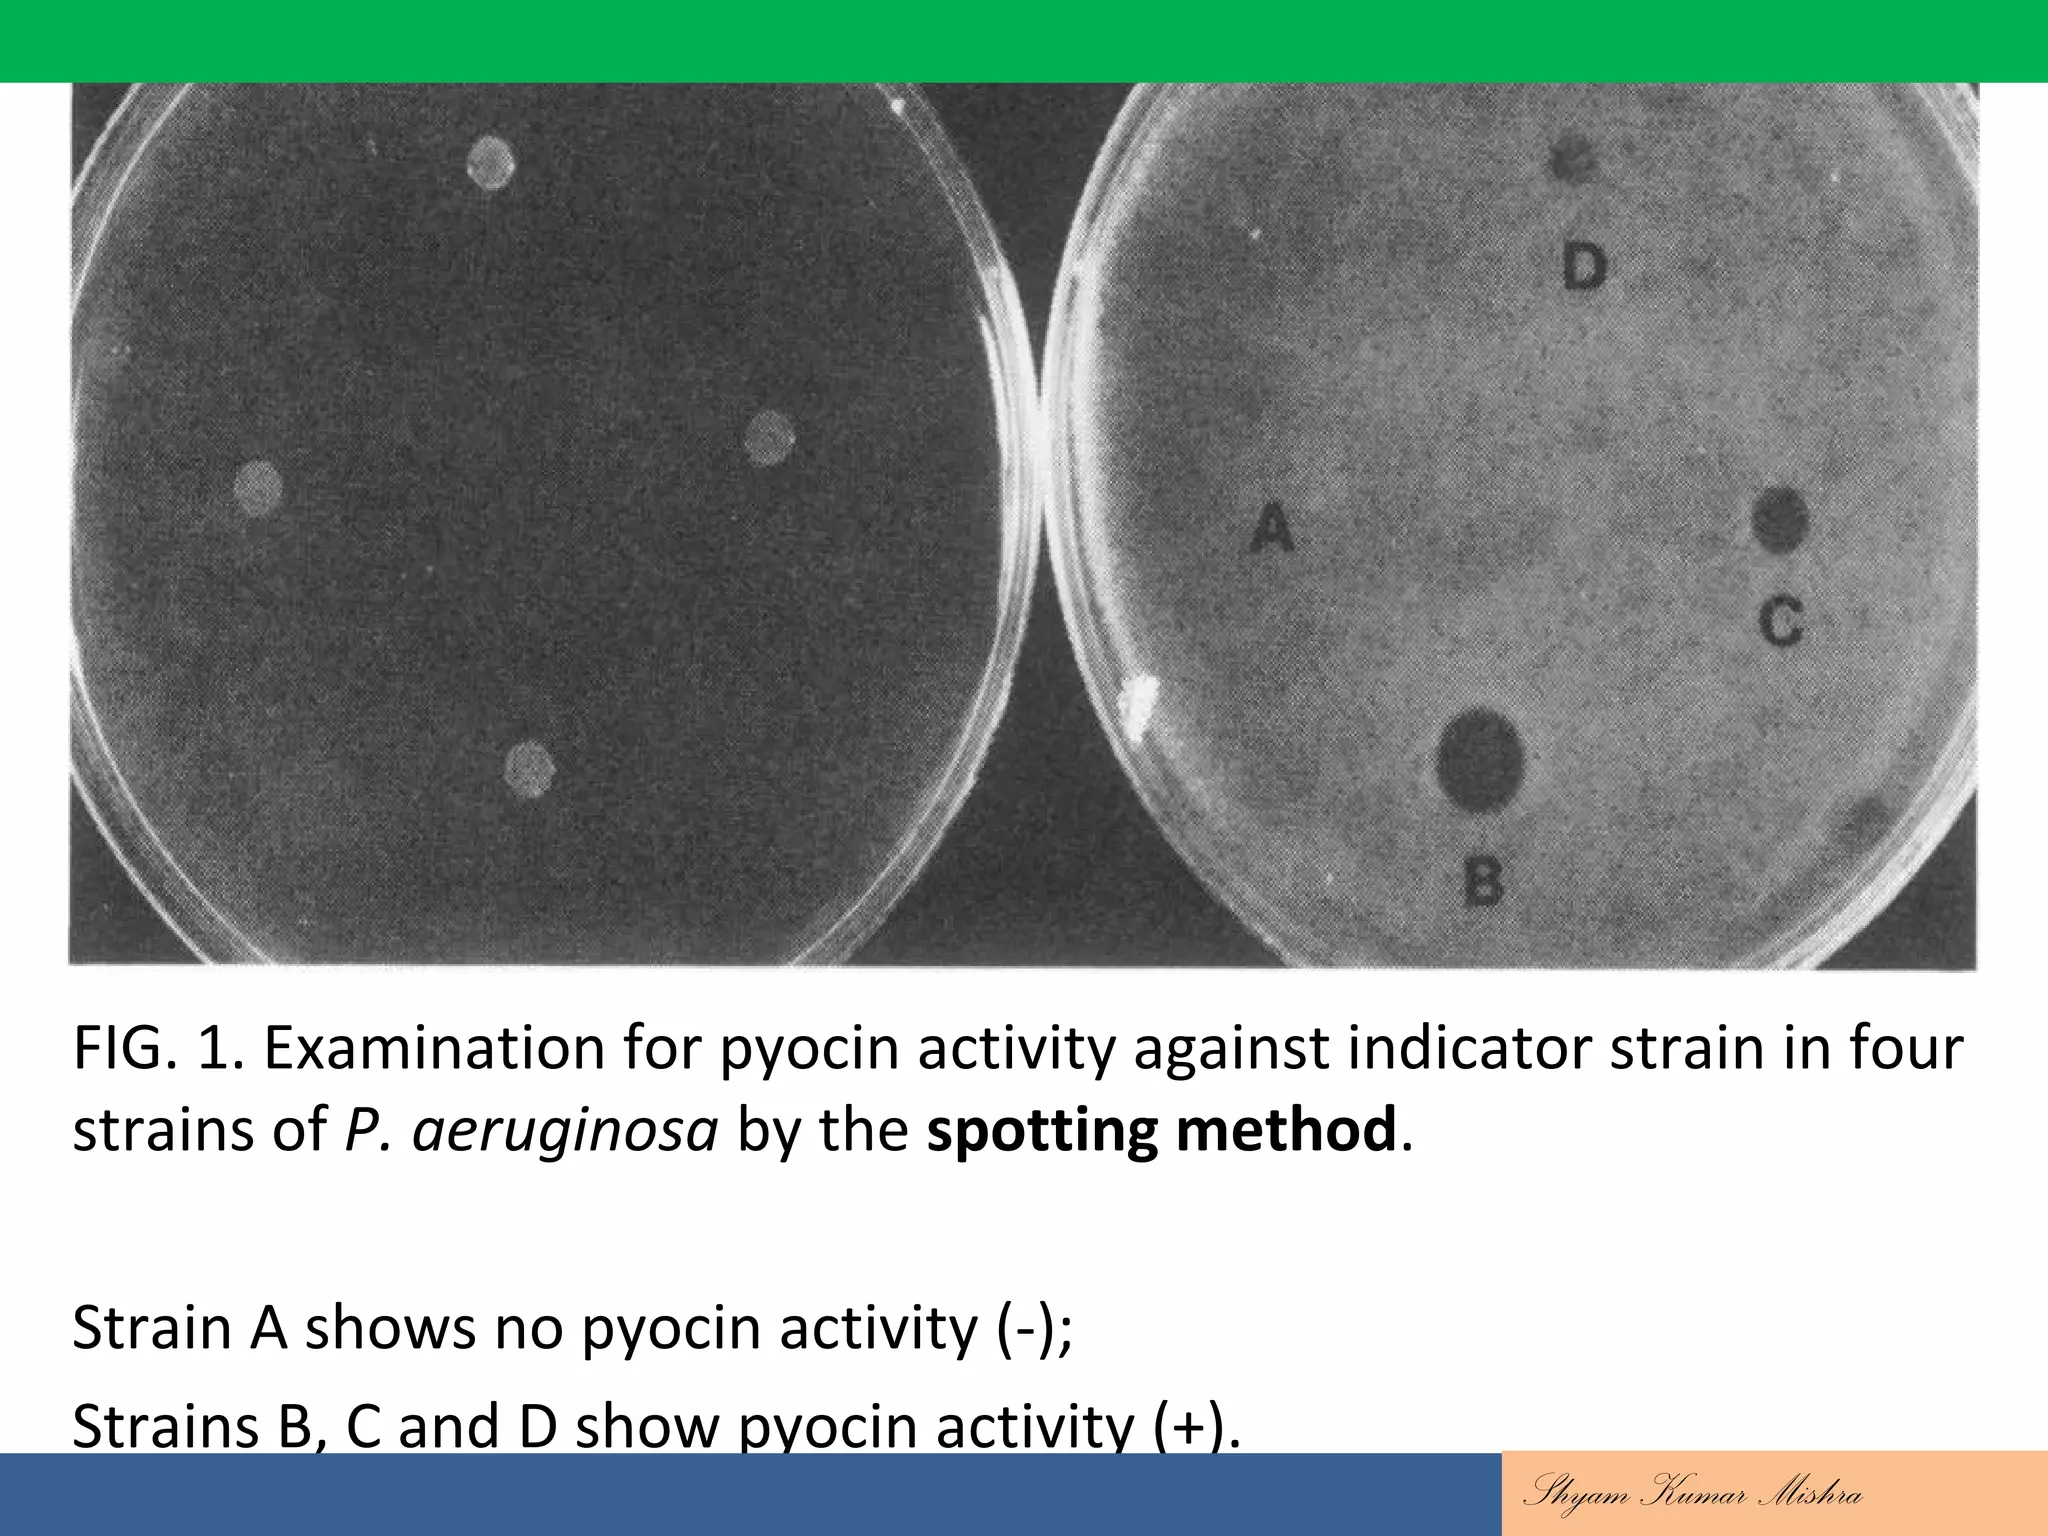
FIG. 1. Examination for pyocin activity against indicator strain in four
strains of P. aeruginosa by the spotting method.
Strain A shows no pyocin activity (-);
Strains B, C and D show pyocin activity (+).
Shyam Kumar Mishra
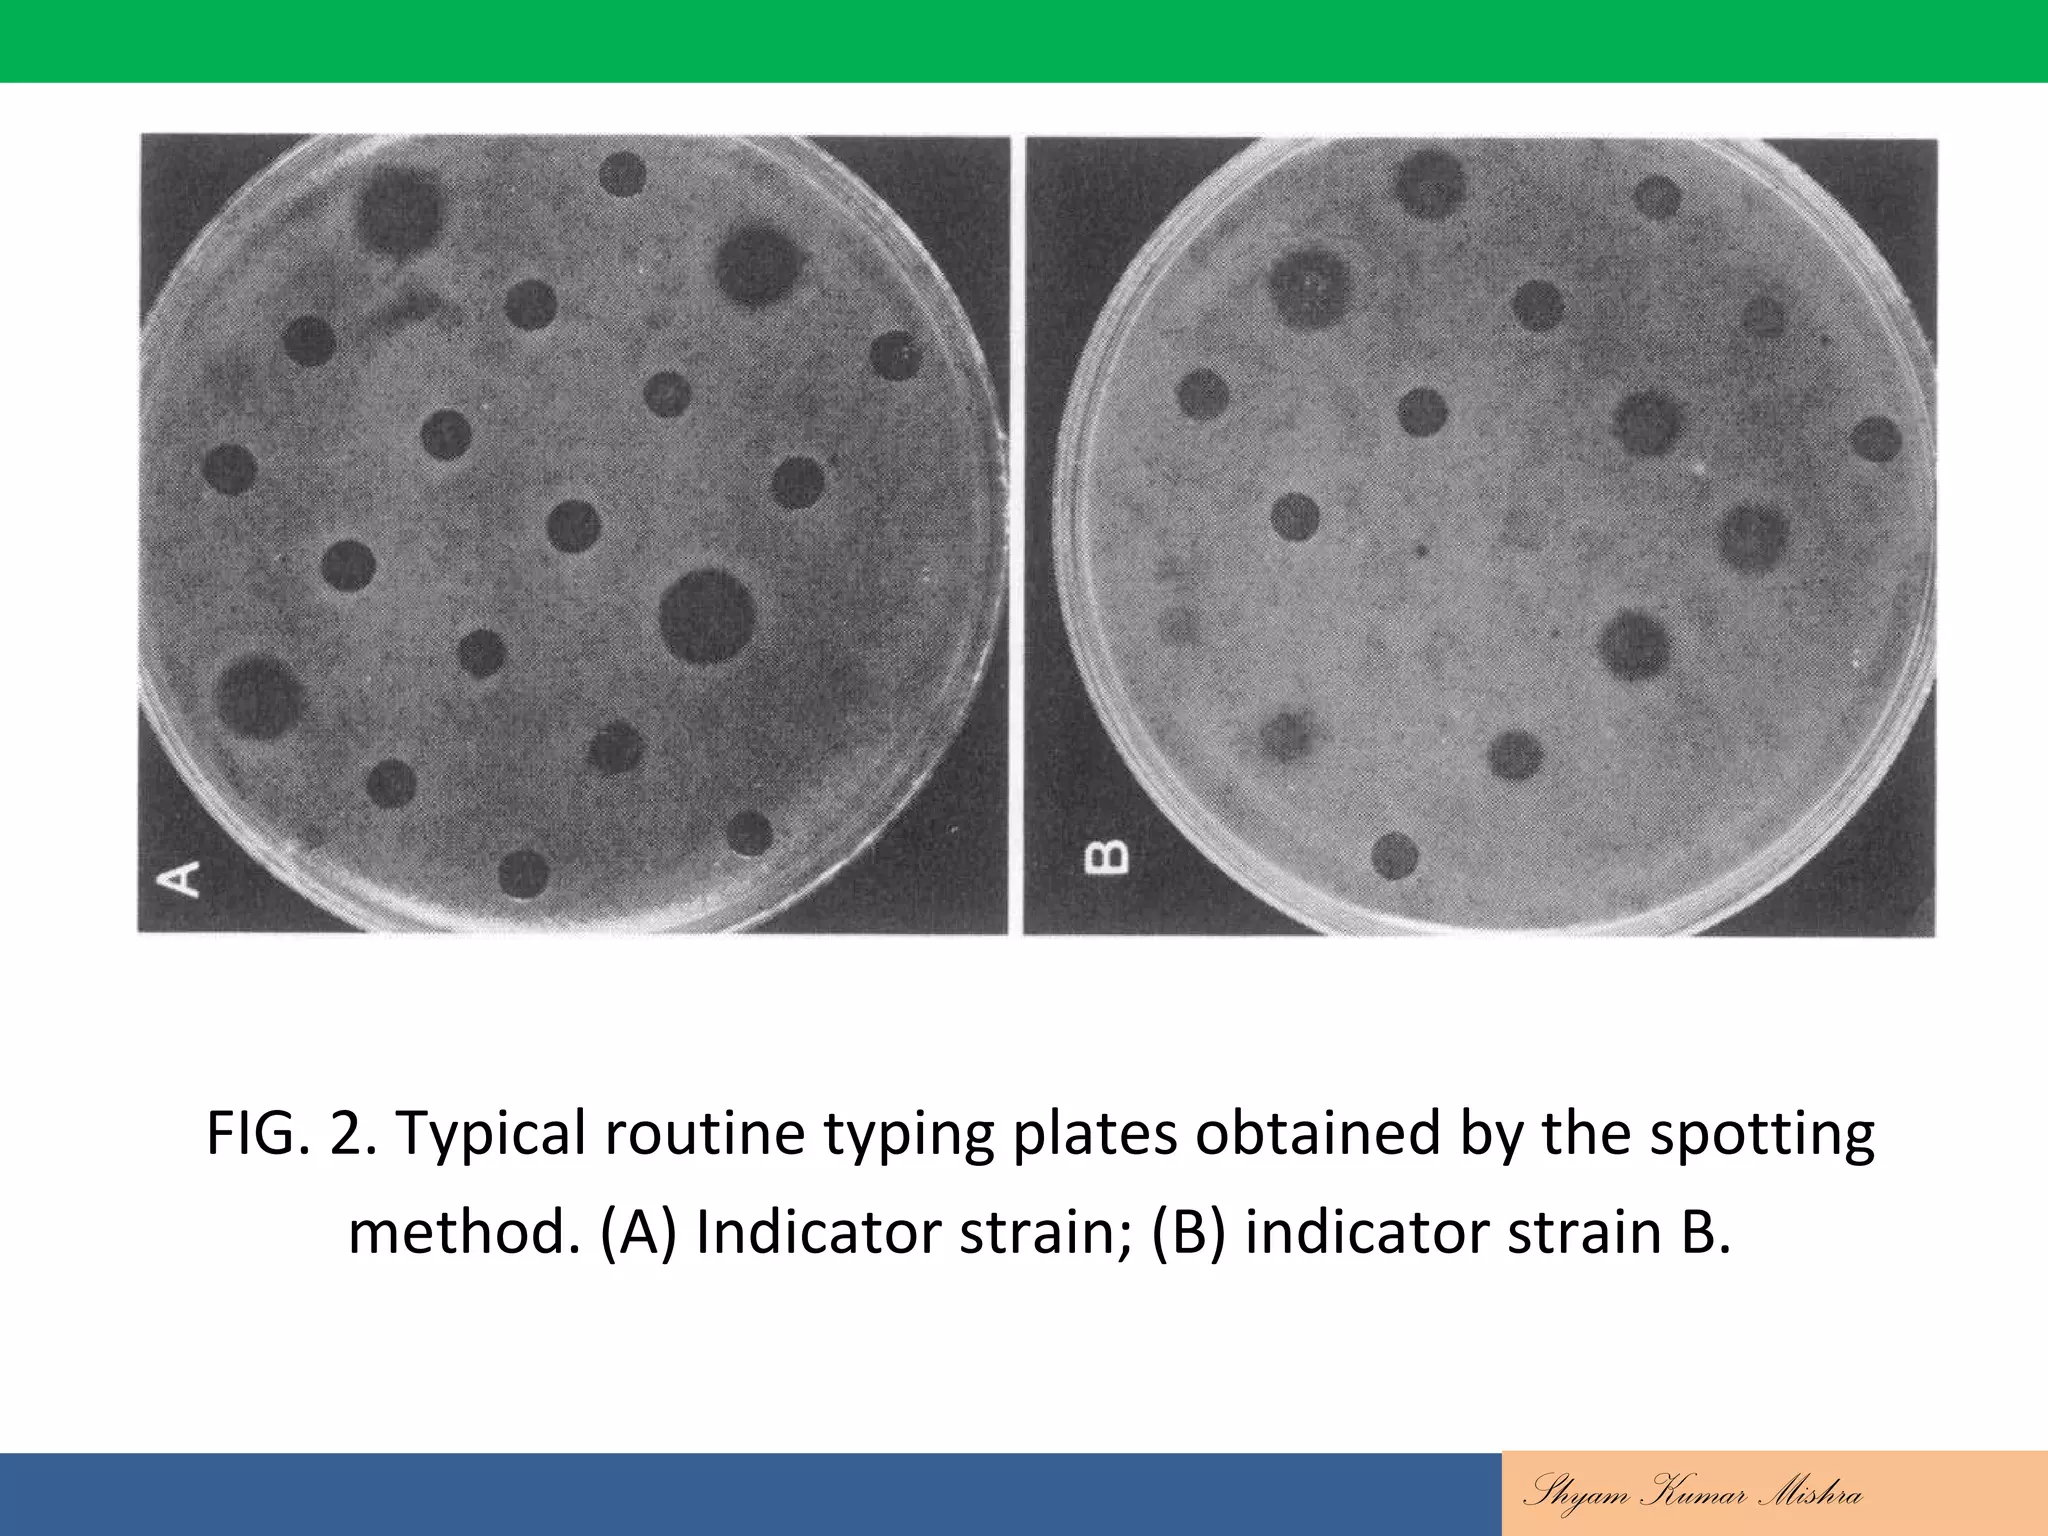
FIG. 2. Typical routine typing plates obtained by the spotting
method. (A) Indicator strain; (B) indicator strain B.
Shyam Kumar Mishra

This document discusses bacteriocin typing for epidemiological investigations. It defines bacteriocins as bactericidal proteins produced by bacteria that kill closely related bacterial strains. Bacteriocin typing involves determining the bacteriocin production patterns of strains against indicator strains or testing strains for susceptibility to different bacteriocins. This allows differentiation of bacterial isolates and investigation of outbreaks. Specific examples discussed are colicin typing of E. coli and pyocin typing of P. aeruginosa. The document outlines the methods for these typing techniques.